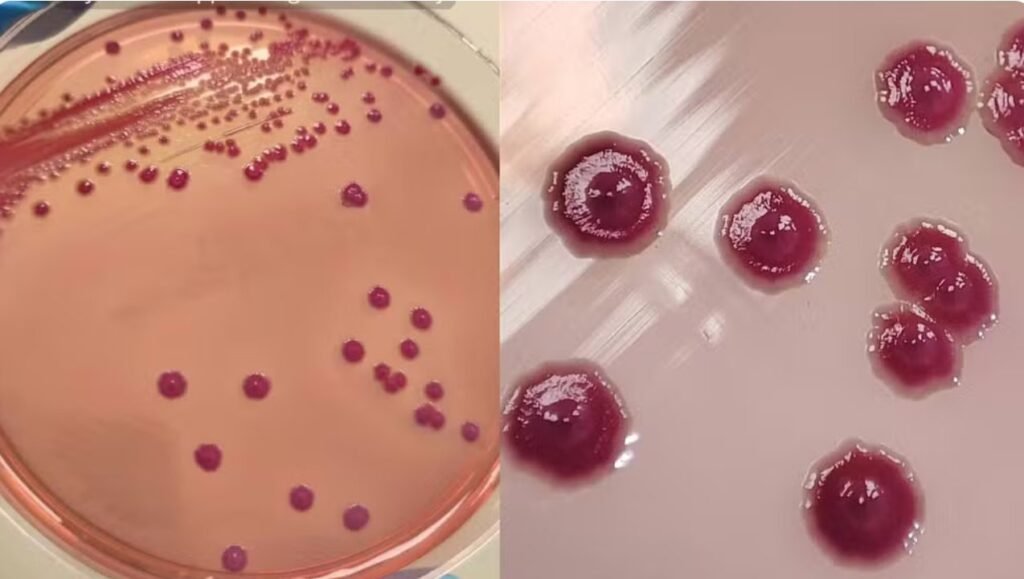

Investigação sobre contaminação em nutrição parenteral que matou 15 prematuros no Brasil revelou o microrganismo emergente Phytobacter diazotrophicus e levou à revisão de métodos de diagnóstico em laboratórios.
Um surto de sepse que atingiu 65 recém-nascidos no Brasil, em 2013, levando à morte de 15 prematuros, ajudou a revelar a presença de uma bactéria emergente e de difícil identificação, que ainda pode estar sendo confundida com outros microrganismos em exames laboratoriais.
O Phytobacter diazotrophicus ainda pode ser identificado como Pantoea em muitos laboratórios, tanto no Brasil quanto no exterior, segundo o microbiologista brasileiro Marcelo Pillonetto. Isso ocorre porque sistemas automatizados de identificação e testes bioquímicos muitas vezes classificam erroneamente espécies do gênero.
A história dessa descoberta foi recontada no documentário “A Saga do Phytobacter”, lançado neste ano e financiado pela Secretaria de Estado da Ciência, Tecnologia e Ensino Superior (Seti) do estado do Paraná.
Mesmo os equipamentos automatizados mais modernos, que utilizam a chamada espectrometria de massa, estão presentes em apenas cerca de 10% dos aproximadamente 20 mil laboratórios nacionais. E o sequenciamento genético – técnica mais eficaz e cara depois desta – ainda é restrita a laboratórios centrais de pesquisa dos estados e a alguns hospitais privados de alta complexidade.
A investigação sobre a contaminação de 2013 levou à revisão de métodos de diagnóstico em laboratórios e a saga foi registrada em um documentário lançado neste ano.
A ORIGEM: O surto ocorreu de outubro de 2013 a maio de 2014, em quatro estados – Paraná, Minas Gerais São Paulo e Rio Grande do Sul – e foi associado à nutrição contaminada utilizada em terapias intravenosas hospitalares. Inicialmente, as amostras analisadas indicaram a presença da bactéria Pantoea, mas o microrganismo era, na verdade, Phytobacter diazotrophicus — sendo este o primeiro relato de infecção por essa espécie em humanos.
A identificação de que a nomenclatura estava incorreta ocorreu após testes realizados pelo Laboratório Central do Paraná (Lacen/PR), que faz parte da rede oficial do Sistema Único de Saúde (SUS), em uma investigação científica liderada por Pillonetto, em parceria com a Universidade de Ciências Aplicadas de Zurique (ZHAW).
A espécie Phytobacter diazotrophicus foi descrita originalmente na China, em 2008, em plantações de arroz, mas sua capacidade de causar doenças em humanos só foi confirmada após os estudos detalhados no Brasil.
A confusão entre as espécies ocorreu porque os métodos tradicionais e os equipamentos automatizados usados na rotina dos hospitais muitas vezes não conseguem distinguir o Phytobacter de seus “parentes” próximos, explicou Pillonetto ao g1. Análises posteriores mostraram que genomas bacterianos depositados em bancos de dados internacionais de coleções de culturas de referência global estavam, desde 1974, com nomes incorretos.
A descoberta foi comunicada oficialmente em 2018, e os pesquisadores trabalharam para atualizar equipamentos laboratoriais. Em 2023, ela foi incluída no banco de dados de um fabricante de espectrometria de massa — método mais moderno e rápido de identificação bacteriana.
Em 2023, houve um surto menor da mesma bactéria, em São José dos Pinhais (região metropolitana de Curitiba), em uma clínica de hemodiálise. Quatro pacientes tiveram sepse, e felizmente todos sobreviveram.
Descoberta de bactéria emergente cria desafios para laboratórios
Segundo Pillonetto, a identificação correta da bactéria gerou um alerta entre microbiologistas e levou à distribuição de amostras para cerca de 300 laboratórios no Brasil e no exterior. O objetivo é que os profissionais de saúde aprendam a reconhecer esse novo inimigo.
“Na prática, essa pesquisa chama a atenção para um patógeno emergente, que vinha sendo confundido com várias outras espécies. O conhecimento aprofundado desta espécie permite diagnósticos precisos e imediatos, além da escolha do antibiótico adequado, o que é crucial em casos de infecção generalizada. Mas ainda há um desconhecimento significativo”, destaca o pesquisador.
Estudos apontam que bactérias do gênero Phytobacter podem estar sendo frequentemente identificadas de forma incorreta em amostras clínicas, porque métodos laboratoriais tradicionais podem confundir esses microrganismos com espécies de outros gêneros, como:
- Enterobacter
- Kluyvera
- Pantoea
- Citrobacter
A confusão taxonômica pode dificultar o reconhecimento de surtos hospitalares e levar à subnotificação da presença dessas bactérias.
“A dificuldade não é porque ela não cresce no laboratório, mas sim porque se disfarça bem. Sem tecnologias avançadas de genética ou equipamentos de ponta, como a espectrometria de massa, essa bactéria passa despercebida. E ela tem uma capacidade preocupante de se espalhar em ambientes hospitalares por meio de soluções contaminadas ou superfícies”, explica Pillonetto.
O que é considerado “padrão ouro” na identificação
Quando hospitais precisam identificar bactérias em exames, sistemas automatizados usados na maioria dos laboratórios nem sempre conseguem identificar espécies complexas e emergentes. Os aparelhos têm em seus bancos de dados diversas bactérias já conhecidas, mas, quando não há identificação, o ideal é recorrer ao chamado “padrão ouro” da microbiologia: o sequenciamento genético.
Esse sequenciamento permite reduzir o tempo de identificação de cerca de 72 horas para 24 horas, além de indicar se a bactéria sofreu modificações e qual é seu perfil de resistência, permitindo a escolha mais precisa do antibiótico. No entanto, essa tecnologia ainda é restrita a laboratórios de pesquisa e a alguns hospitais privados de alta complexidade.
Isso ocorre porque os kits usados no sequenciamento são produzidos no exterior e ainda têm custo elevado, principalmente devido aos altos impostos, segundo especialistas ouvidos pelo g1.
Mesmo equipamentos automatizados mais modernos, que utilizam espectrometria de massa, estão presentes em apenas cerca de 10% dos aproximadamente 20 mil laboratórios brasileiros.
O professor do Departamento de Microbiologia do ICB-USP, Nilton Lincopan, afirma que as ferramentas genômicas ainda são onerosas e exigem mão de obra qualificada, mas são essenciais para identificar bactérias emergentes. Uma alternativa viável, segundo ele, seria aproximar laboratórios públicos e hospitais dos centros de pesquisa das universidades.
O kit adquirido mais recentemente pela equipe de Lincopan para sequenciar 96 bactérias, por exemplo, custou R$ 75 mil. Após aberto, o material perde a validade, o que exige o acúmulo de amostras para melhor aproveitamento — o que pode atrasar diagnósticos.
Já existem kits capazes de analisar 24 bactérias, mas nem sempre estão disponíveis nos centros de referência.
“Talvez esses próprios laboratórios-escola poderiam ser referência para cada região, e o sistema público de saúde não teria gastos com infraestrutura e mão de obra qualificada. Por outro lado, o laboratório-escola realizaria seu papel em termos de extensão universitária”, sugere Lincopan.
O microbiologista avalia que essa integração permitiria transformar dados em pesquisa aplicada, contribuindo para o enfrentamento de desafios como resistência bacteriana, surtos hospitalares e diagnóstico precoce.
Pillonetto destaca que a identificação precisa do Phytobacter é vital, pois o microrganismo tem demonstrado capacidade crescente de adquirir genes de resistência a antibióticos potentes.
O especialista acrescenta que é fundamental que as instituições invistam em equipamentos adequados e na capacitação de profissionais para melhorar a identificação de microrganismos, reduzir erros diagnósticos e enfrentar a resistência antimicrobiana.
Da confusão à identificação correta
Inicialmente, os microrganismos responsáveis pelo surto de 2013 foram classificados como Acinetobacter baumannii, Rhizobium radiobacter, Pantoea ou outras bactérias da família Enterobacteriaceae.
Mas análises moleculares mais detalhadas mostraram que parte dos isolados correspondia, na realidade, à espécie Phytobacter diazotrophicus.
O estudo confirmou a presença de três bactérias envolvidas no surto:
- Acinetobacter baumannii
- Phytobacter diazotrophicus
- Rhizobium radiobacter
As análises genéticas indicaram que as duas primeiras eram muito semelhantes, sugerindo uma origem comum de contaminação. Em um dos pacientes, as três espécies foram detectadas simultaneamente.
Presença em hospitais e unidades neonatais
Estudos em diferentes países têm detectado espécies do gênero Phytobacter em ambientes hospitalares.
Em Singapura, pesquisadores encontraram duas amostras de Phytobacter diazotrophicus em uma UTI neonatal, coletadas em uma torneira e no sifão da pia de uma sala de preparo de leite.
Inicialmente, as bactérias foram identificadas incorretamente como Cronobacter sakazakii e Klebsiella oxytoca. A identidade real só foi confirmada após sequenciamento completo do genoma.
Segundo pesquisadores, bactérias desse grupo são encontradas tanto em ambientes naturais quanto em contextos clínicos e vêm sendo cada vez mais relatadas em infecções humanas.
Potencial de resistência a antibióticos
Pesquisas apontam que algumas espécies do gênero podem carregar genes de resistência a antibióticos de última linha.
Um estudo publicado na revista científica “Microbiology Spectrum” identificou oPhytobacter diazotrophicus em pacientes pediátricos e em ambientes hospitalares no Japão. As amostras apresentavam o gene blaNDM-1, associado à resistência a carbapenêmicos.
Outro trabalho relatou genes ligados à resistência à colistina e à produção de carbapenemase, reforçando a preocupação com o potencial do microrganismo.
Casos clínicos e infecções raras
Além de surtos hospitalares, há registros de infecções isoladas associadas ao gênero.
Um relato publicado no periódico científico “BMJ” descreveu um caso de sepse causado por Phytobacter ursingii em uma paciente idosa que recebia nutrição venosa.
Outro estudo descreveu um caso de sepse neonatal na China causada por Phytobacter diazotrophicus em uma bebê de 27 dias com galactosemia tipo 1.
Segundo os pesquisadores, o microrganismo é considerado um patógeno oportunista e já foi isolado em sangue humano, fluidos intravenosos e águas residuais hospitalares.
Para Pillonetto, o episódio do surto de 2013 no Brasil e a identificação correta da bactéria reforçam a necessidade de atualização dos laboratórios clínicos.